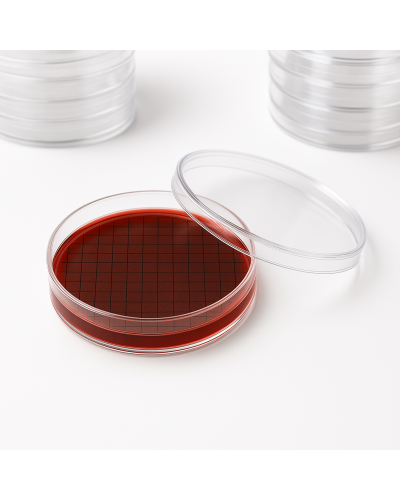
Boîtes de pétri pour hygiène, 12ml, stérile

Boîtes de pétri pour hygiène, 12ml, stérile
Boîtes de pétri pour hygiène, 12ml; stérile
- Boîte de Pétri "Contact" en polystyrène cristal.
- Cette boîte s'adresse principalement aux laboratoires de contrôle: des industries alimentaires, des vétérinaires, de l'industrie pharmaceutique, de culture cellulaire, des centres hospitaliers (pour contrôle d'hygiène des blocs opératoires et des cuisines par ex.), des collectivités.
- La boîte "Contact" est utilisée pour les contrôles de l'environnement afin de déterminer la contamination microbienne globale ou spécifique de surfaces variées comme la peau, blocs opératoires, cuisines, paillasses.
- La gélose, coulée sur ce support froid ou réfrigéré pour faciliter la formation d'un ménisque convexe, sera appliquée au contact de la surface à contrôler.
- Les germes éventuellement présents adhèrent à la gélose, et après incubation,le dénombrement des colonies est ramené au centimètre carré de la surface contrôlée grâce au quadrillage 10 x 10 mm de la boîte.
Dimension(Ø x H) des boîtes de pétri pour hygiène: 65 x 14,45.
Conditionnement: Carton de 48 sachets de 15 pièces.
Condition minimum de vente: Carton 720 pièces.
 Des milliers de références
Des milliers de références
de marques au meilleur prix
 Livraison gratuite dès 125€
Livraison gratuite dès 125€
en France métropolitaine
 Paiements sécurisés
Paiements sécurisés
CB & Paypal
 Une équipe dédiée
Une équipe dédiée
Service client gratuit et personnalisé
Boîtes de pétri pour hygiène, 12ml; stérile
- Boîte de Pétri "Contact" en polystyrène cristal.
- Cette boîte s'adresse principalement aux laboratoires de contrôle: des industries alimentaires, des vétérinaires, de l'industrie pharmaceutique, de culture cellulaire, des centres hospitaliers (pour contrôle d'hygiène des blocs opératoires et des cuisines par ex.), des collectivités.
- La boîte "Contact" est utilisée pour les contrôles de l'environnement afin de déterminer la contamination microbienne globale ou spécifique de surfaces variées comme la peau, blocs opératoires, cuisines, paillasses.
- La gélose, coulée sur ce support froid ou réfrigéré pour faciliter la formation d'un ménisque convexe, sera appliquée au contact de la surface à contrôler.
- Les germes éventuellement présents adhèrent à la gélose, et après incubation,le dénombrement des colonies est ramené au centimètre carré de la surface contrôlée grâce au quadrillage 10 x 10 mm de la boîte.
Dimension(Ø x H) des boîtes de pétri pour hygiène: 65 x 14,45.
Conditionnement: Carton de 48 sachets de 15 pièces.
Condition minimum de vente: Carton 720 pièces.
Fiche technique
- Color
- Conditionnement
- Capacité
- Reférence
- Incrément
- Dimensions
- Stérile
- Modèle
- Pour partie
- Capacité des cônes
- Couvercle PVC
- delais
- 48 heures
- Demande de devis
- Allowed to Quote Mode
- Conformité CE
- Conformité NF
- Garantie
- 0
- Produit gynemat